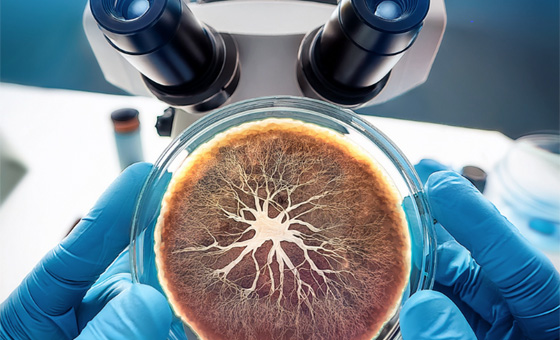

「臺灣鵝絨」軟黃金的溫暖旅程 從農廢到50倍價值的隱形臺灣之光
臺灣鵝絨從農業副產品躍升為「軟黃金」,透過精洗、分級等多道工序,將原本低價的水毛提升為高蓬鬆度、高純度的保暖材料,附加價值高達 50 倍。臺灣以白羅曼鵝為主,鵝絨品質因養殖天數與氣候受到影響,但在中游精加工後可達 95% 純度與 700+ 蓬鬆度,廣泛用於高端羽絨被、睡袋與服飾;CAS 認證強調新鮮度、品質一致性與溯源,成為臺灣鵝絨的重要競爭力與出口亮點。
MENU
根瘤線蟲(Root knot nematode)一直以來都是農業生產的重大威脅,每年都造成數十億美元的農業損失。這些寄生蟲可在植物根部誘導形成瘤結,雖然這是植物生命週期的關鍵部分,卻會嚴重損害寄主植物的健康。有鑑於線蟲感染對經濟和環境所造成的深遠影響,深入研究這些寄生蟲如何改變寄主植物的遺傳機制就變得較為迫切。美國田納西大學(University of Tennessee)研究團隊探討了南方根瘤線蟲(Meloidogyne incognita)感染番茄植物後引發的分子變化,著重分析根瘤的局部和周圍組織中的轉錄和剪接反應,闡述線蟲如何劫持植物的遺傳機制創造有利的生存環境。
研究團隊透過深入分析番茄植物對根瘤線蟲的感染反應,在根瘤和鄰近根組織部分識別出大量差異表現基因(differentially expressed genes, DEGs),發現了一個由線蟲觸發的精密調控網路。研究發現,線蟲感染會導致根瘤和鄰近細胞的基因表達發生協同變化,產出一個支持線蟲發育的複雜細胞通訊系統。
後續研究選擇性剪接事件,線蟲感染能調節訊息RNA的剪接,由此影響基因功能和蛋白質多樣性。透過驗證轉基因毛狀根系統,確定這些RNA的剪接在根瘤形成和線蟲產卵過程中扮演關鍵角色,揭開線蟲操縱寄主植物的精密分子機制。
這項研究首次深入了解根瘤線蟲如何重新改變番茄植物的遺傳機制,這些發現不僅加深對植物與寄生蟲共同協作的理解,也為開發創新的生物防治策略提供了新思考方向,對農業有著深遠的影響,可以開發對寄生蟲有更強抵抗力的作物品種,有望可減少作物損失,並提高產量穩定性,為全球糧食安全和農業永續發展做出重要貢獻。【延伸閱讀】-開發長豆的抗蟲害新品種,減少農藥使用